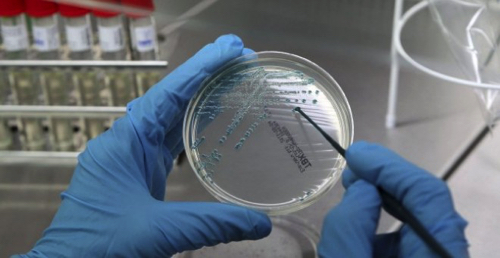
577f8425ad2df

El director de l’Institut Sloan Kettering de Nova York, l’oncòleg català Joan Massagué, ha afirmat aquest divendres que la ciència està “a dues o tres dècades de donar un tomb al càncer, de portar-lo al mateix estadi que les infeccions amb la penicil·lina”.
En declaracions a TV3, Massagué ha assegurat que la ciència ha fet “grans avenços” en la lluita contra el càncer. “Estem en un segment, que és de dues o tres dècades, per donar un tomb al càncer, per portar-lo en aquest estadi al que portem les infeccions amb el descobriment de la penicil·lina i altres antibiòtics específics durant les tres o quatre dècades centrals del segle XX “, ha dit l’oncòleg.
Segons Massagué, en “els últims dos anys hi ha hagut grans avanços a través de reactivar la immunitat perquè acabi de fer la feina que se li va escapar, que és la d’eliminar el tumor quan és petit”.
“S’estan guarint milers de persones amb una immunitat reforçada, a més de administrar fàrmacs que actuen directament contra el tumor. Però només en determinats càncers”, ha puntualitzat el doctor Massagué, que ahir a la nit va recollir el premi que li ha concedit la Societat Catalana de Biologia per la seva contribució a la difusió de les ciències biològiques.
Massagué ha avançat que “ara el que estem fent són estudis per determinar per què s’aconsegueix en uns càncers i no en altres. I per què s’aconsegueix en unes persones i no en altres.” Estem aquí “, ha conclòs.

